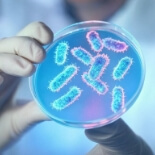

解決方案 ⬝ 服務項目
SERVICE
解決方案 ⬝ 博物館
Museum
針對博物館之蒐藏研究、展示推廣與營運服務等業務需求
本公司提供文物典藏管理系統、標本典藏管理系統、數位內容管理系統、會員管理系統,以及數位博物館加值應用服務等資訊系統解決方案。

1
研究典藏
- 數位典藏
- 推薦服務
- 庫房管理
- 整合查詢
- 藏品管理
- 數位內容

2
數位內容管理
- 全館多媒體管理
- 跨領域數位資源管理

3
整合式內容服務
- 博物館虛實整合服務
- 行動數位典藏服務
- 開放資料服務

4
館際合作
- 聯合目錄
解決方案 ⬝ 公共衛生
Public Health
以全方位民眾健康照護為理想
秉持「以人為本,家戶為中心」為宗旨
秉持「以人為本,家戶為中心」為宗旨
以健康資料整合、垂直與水平資料介接、落實資料保護、行動服務應用等技術為核心,提供公共衛生業務資訊管理之完整解決方案。

1
便民服務
- 失智症服務網
- 行動化公衛服務
- 兒童早期療育服務網
- 嬰幼兒預防接種簡訊
2
疾病管制
- 腸病毒
- AIDS
- 社區心理衛生管理
- 精神衛生管理

3
衛生管理
- 營業衛生管理
- 職業衛生管理

4
食藥管理
- 長期照護藥事服務管理
- 藥妝廣告查詢申辦管理
- 食藥粧網路地圖服務管理
- 行動化聯合稽查管理
- 檢驗行政管理

5
資訊服務
- 問題單管理
- 資訊系統公用平台

6
健康照護
- 長期照護志工資訊網

7
篩檢管理
- 老人健康檢查管理

8
醫事醫療
- 早期療育管理
- 兒童醫療補助管理
